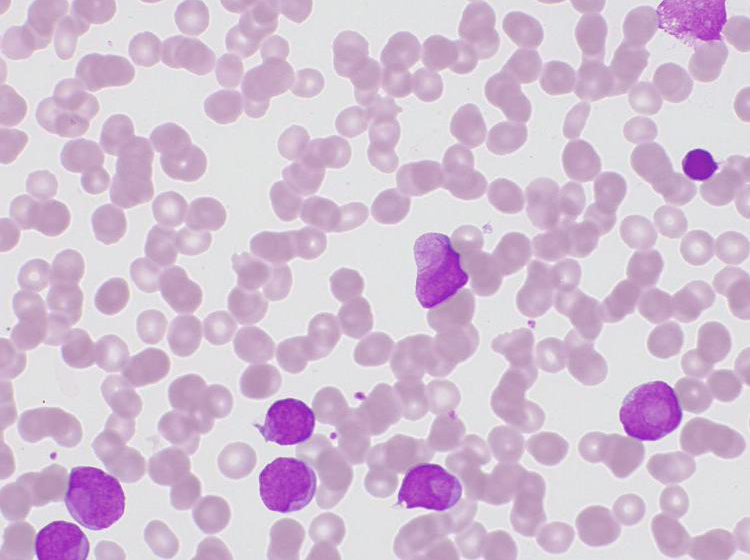
Bone marrow in brightfield, Auer rod. Acquired with ZEISS Axioscope 5

Microscopy Solutions for Hematology
Microscopy applications for your laboratory
Blood consists of several components, including erythrocytes (red blood cells), leukocytes (white blood cells), thrombocytes (platelets) and plasma. All of the aforementioned cell types are produced in the bone marrow from multipotent precursor cells in a process called hematopoiesis.
Erythrocytes, which are disc-shaped and make up about 45% of whole blood, carry oxygen from the lungs to the body’s tissues and organs while also transporting carbon dioxide back to the lungs to be exhaled. Leukocytes are the cells of the immune system that are involved in protecting the body against both infectious disease and foreign invaders. Thrombocytes are small, colorless fragments that stick together and interact with coagulation factors to stop bleeding from blood vessel injury. Together with leukocytes, they make up less than 1% of whole blood volume. The fluid part of the blood, the plasma, is composed of 92% water and contains vital proteins, mineral salts, sugars, fats, hormones and vitamins.
Hematologists routinely investigate peripheral blood smears on glass slides with a microscope to find any abnormalities indicating hematological diseases or to look for blood parasites, such as those found for malaria and filariasis. The blood smear is dried, fixed to the slide with methanol, and stained to distinguish the various cell types. In hematology most staining techniques are Romanowski stains such as Wright’s stain, Giemsa stain, or a combination of both to detect erythrocyte, leukocyte or thrombocyte abnormalities. Light microscopy with a magnification of up to 1.000x is employed to recognize and count the various cell types within a monolayer and document the results with a digital camera. This way, many types of anemia as well as leukemia or the developmental stages of the malaria parasite Plasmodium falciparum can be detected. In certain cases, the microscopic study of the peripheral blood smear is complemented by a bone marrow examination.
Microscopy Solutions for Hematology
Microscope Requirements
When examining a peripheral blood smear, a hematologist starts with a low magnification objective, typically a 20x or 10x. The hematologist gets an overview of red and white blood cell densities, the amount of erythrocytes, its color and rough morphology and if obvious cellular inclusions are present. In higher magnification (typically 60x or 100x, sometimes 40x for bone marrow), a manual differential cell count is performed and red and white blood cell morphology including the presence of inclusions or parasites are assessed. A very good differentiation of cell types and clearly visible cellular details are absolute prerequisites in hematology. Hematologists rely on crystal-clear images to visualize morphological details such as delicate granules, Auer rods, irregularities of the nuclear membrane or clefted nuclei.
Furthermore, highest color fidelity is key when examining blood smears and bone marrow preparations. Apart from brightfield microscopy phase contrast and polarizing microscopy techniques are also used for certain types of samples. While hematological stains result in a good transparency of the sample and specific staining of cellular features, it is the optical quality of the microscope, the fidelity of the attached camera for digital documentation, and the ergonomic design of the instrument that can make all the difference when screening patient samples.
Created by Carl Zeiss Microscopy GmbH
Application Examples